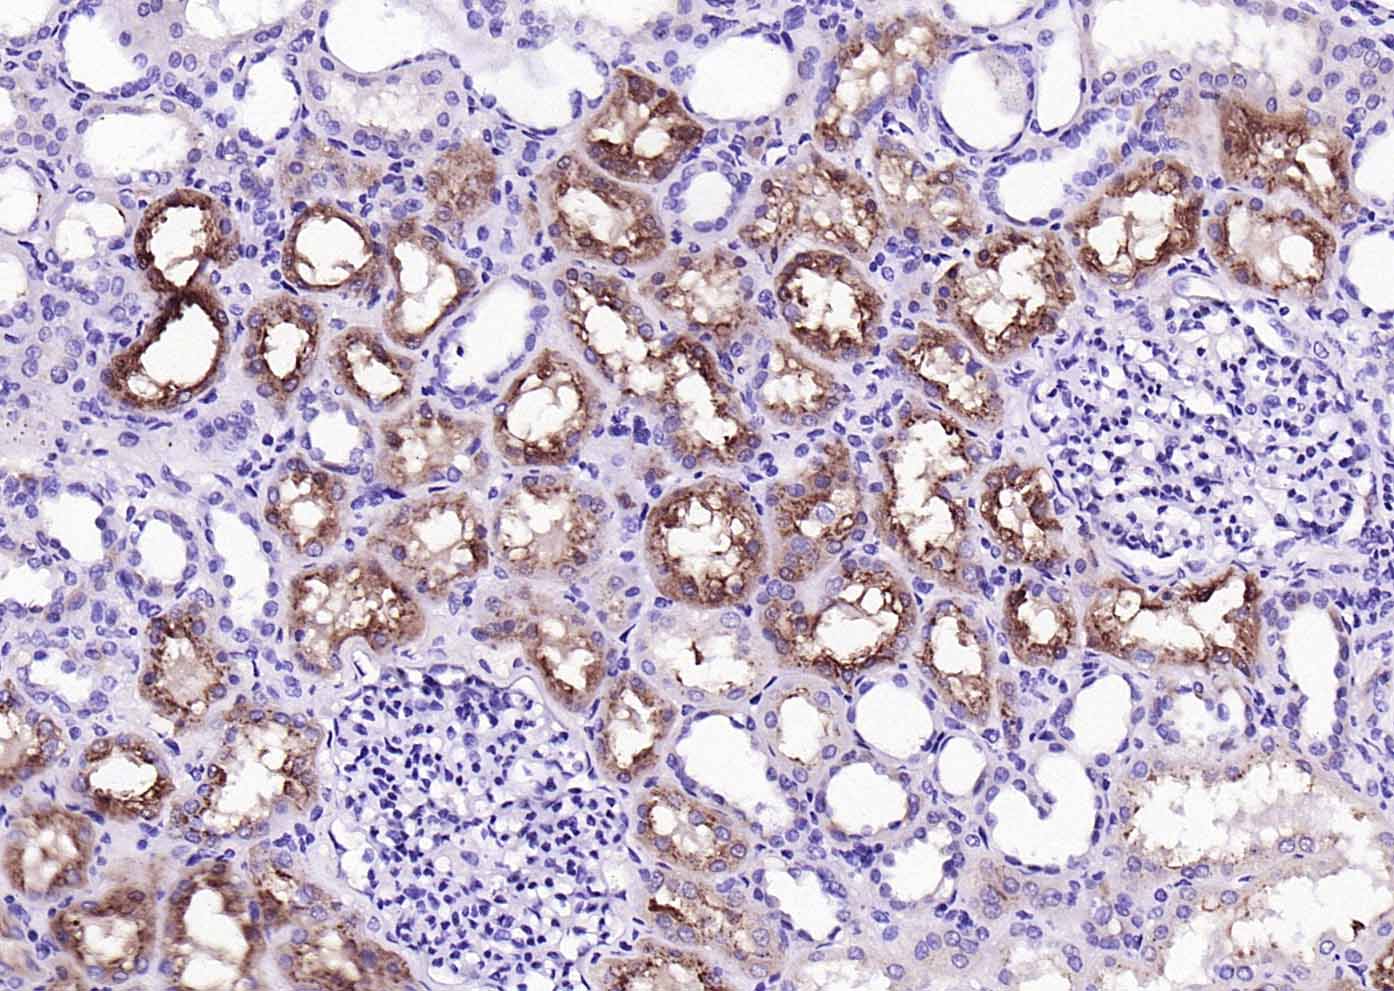
RBP4 Mouse mAb(bsm-43011M)-50u

相关产品推荐更多 >

EpCAM Rabbit pAb, HRP conjugated(bs-1513R-HRP)-100ul
¥2980
phospho-HSP27 (Ser82) Rabbit pAb, FITC conjugated(bs-3180R-FITC)-100ul
¥2980
AFAP1L2 Rabbit pAb, APC conjugated(bs-11020R-APC)-100ul
¥2980
phospho-Serine/Threonine Rabbit pAb, AP conjugated(bs-11994R-AP)-100ul
¥2980
LRRC25 Rabbit pAb(bs-12339R)-50ul/100ul/200ul
¥1180
万千商家帮你免费找货
0 人在求购买到急需产品
- 详细信息
- 技术资料
- 应用范围:
产品信息以Bioss网站为准
- 规格:
50ul/100ul/200ul/200ug
| 规格: | 50ul | 产品价格: | ¥1180.0 |
|---|---|---|---|
| 规格: | 100ul | 产品价格: | ¥1980.0 |
| 规格: | 200ul | 产品价格: | ¥2800.0 |
| 规格: | 200ug | 产品价格: | ¥5600.0 |
| 产品编号 | bsm-43011M |
| 英文名称 | RBP4 Mouse mAb |
| 中文名称 | 视黄醇结合蛋白4单克隆抗体 |
| 英文别名 | plasma retinol binding protein 4; Plasma retinol-binding proteinv; Plasma retinol-binding protein(1-176); prbp; PRO2222; RBP; RET4_HUMAN; Retinol binding protein 4; retinol binding protein 4 interstitial; Retinol binding protein 4 plasma. |
| 产品应用 | WB=1:500-2000, IHC-P=1:100-500, IHC-F=1:400-800, IF=1:100-500 Not yet tested in other applications. |
| 交叉反应 | Human |
| 抗体来源 | Mouse |
| 免疫原 | Recombinant human RBP4 protein |
| 亚型 | IgG |
| 性状 | Liquid |
| 纯化方法 | affinity purified by Protein A |
| 克隆类型 | Monoclonal |
| 理论分子量 | 21 kDa |
| 浓度 | 1mg/ml |
| 储存液 | 0.01M PBS (pH7.4). |
| 研究领域 | Cardiovascular > Atherosclerosis > Diabetes associated Cardiovascular > Blood > Serum Proteins Metabolism > Pathways and Processes > Cofactors, Vitamins / minerals > Vitamins / minerals Metabolism > Types of disease > Diabetes Metabolism > Types of disease > Heart disease Signal Transduction > Metabolism > Vitamins / Minerals |
| 亚细胞定位 | Secreted. |
| 相似性 | Belongs to the calycin superfamily. Lipocalin family. |
| 功能 | Delivers retinol from the liver stores to the peripheral tissues. In plasma, the RBP-retinol complex interacts with transthyretin, this prevents its loss by filtration through the kidney glomeruli. |
| 保存条件 | Shipped at 4℃. Store at -20℃ for one year. Avoid repeated freeze/thaw cycles. |
| 注意事项 | This product as supplied is intended for research use only, not for use in human, therapeutic or diagnostic applications. |
| 背景资料 | Retinol binding protein 4, also known as RBP4, is a transporter protein for retinol (vitamin A alcohol). RBP4 has a molecular weight of approximately 21 kDa and is encoded by the RBP4 gene in humans. It is mainly, though not exclusively, synthesized in the liver and circulates in the bloodstream bound to retinol in a complex with transthyretin. RBP4 has been a drug target for ophthalmology research due to its role in vision. RBP4 may also be involved in metabolic diseases as suggested by recent studies. |
| 应用 | 推荐稀释比例 |
| {WB} | {1:500-2000} |
| {IHC-P} | {1:100-500} |
| {IHC-F} | {1:400-800} |
| {IF} | {1:100-500} |

Paraformaldehyde-fixed, paraffin embedded (human liver carcinoma); Antigen retrieval by boiling in sodium citrate buffer (pH6.0) for 15min; Block endogenous peroxidase by 3% hydrogen peroxide for 20 minutes; Blocking buffer (normal goat serum) at 37°C for 30min; Antibody incubation with (RBP4) Monoclonal Antibody, Unconjugated (bsm-43011M) at 1:200 overnight at 4°C, followed by operating according to SP Kit(Mouse)(sp-0024) instructionsand DAB staining.

Paraformaldehyde-fixed, paraffin embedded (Human kidney); Antigen retrieval by boiling in sodium citrate buffer (pH6.0) for 15min; Block endogenous peroxidase by 3% hydrogen peroxide for 20 minutes; Blocking buffer (normal goat serum) at 37°C for 30min; Antibody incubation with (RBP4) Monoclonal Antibody, Unconjugated (bsm-43011M) at 1:200 overnight at 4°C, followed by operating according to SP Kit(Mouse)(sp-0024) instructionsand DAB staining.
Paraformaldehyde-fixed, paraffin embedded (Human renal carcinoma); Antigen retrieval by boiling in sodium citrate buffer (pH6.0) for 15min; Block endogenous peroxidase by 3% hydrogen peroxide for 20 minutes; Blocking buffer (normal goat serum) at 37°C for 30min; Antibody incubation with (RBP4) Monoclonal Antibody, Unconjugated (bsm-43011M) at 1:200 overnight at 4°C, followed by operating according to SP Kit(Mouse)(sp-0024) instructionsand DAB staining.

Sample:
Lane 1: Recombinant human RBP4 protein, His (HEK293)
Primary: Anti-RBP4 (bsm-43011M) at 1/1000 dilution
Secondary: IRDye800CW Goat Anti-Mouse IgG at 1/20000 dilution
Predicted band size: 21 kDa
Observed band size: 21 kDa
Lane 1: Recombinant human RBP4 protein, His (HEK293)
Primary: Anti-RBP4 (bsm-43011M) at 1/1000 dilution
Secondary: IRDye800CW Goat Anti-Mouse IgG at 1/20000 dilution
Predicted band size: 21 kDa
Observed band size: 21 kDa
风险提示:丁香通仅作为第三方平台,为商家信息发布提供平台空间。用户咨询产品时请注意保护个人信息及财产安全,合理判断,谨慎选购商品,商家和用户对交易行为负责。对于医疗器械类产品,请先查证核实企业经营资质和医疗器械产品注册证情况。
技术资料暂无技术资料 索取技术资料
RBP4 Mouse mAb(bsm-43011M)-50ul/100ul/200ul/200ug
¥1180 - 5600





